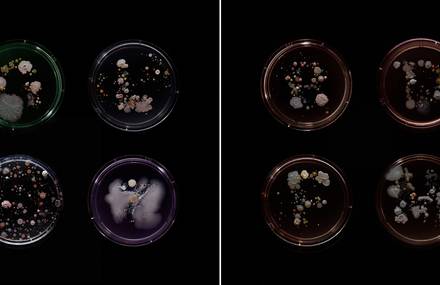

New-York possède l’un des métros les plus célèbres de la planète. Le photographe...
1138
Custom your daily dose of inspiration
Access to exclusive content and new products before everyone else
Add to favorites your articles on Fubiz
New-York possède l’un des métros les plus célèbres de la planète. Le photographe...
1138